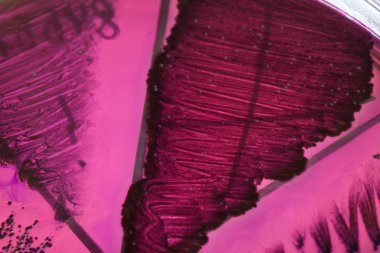
Petri kabındaki bakteriler

Renkli basit arka plan, dalgalı etkisi. Etkisi noktalarla. Ritmik ses parçacıklar. Tahıl doku. Renkli darbeleri ile duvar kağıdı. Duvar iç tasarım, lockscreen, paket için desen
İhlal Bildirim Formu

Özel Boyut
(7952 x 5304, jpg)
Geniş Lisanslama
(7952 x 5304, jpg)
* Kurumsal aylık abonelikte çok avantajlı fiyatlar için tıklayın.
* Fiyatlara Kdv dahil değildir.
Örnek Kullanımlar: Web siteleri; reklam afişleri; ekran koruyucuları; sunumlar (PowerPoint, Flash, vs); filmler, videolar veya televizyon reklamları, gazete ve dergilerdeki reklamlar, bastırılmış reklam materyalleri; kitaplar için kapak, iş kartları; el ilanları; posterler; CD/DVD kapakları, etiketler veya ürün paketleri, kırtasiye, dosya, defterler, tükenmez kalem, kalemler, yapıştırmalar; takvimler; fincanlar veya bardaklar; fare altlığı; tişörtler, kıyafet vs. Detaylı Tablo için Tıklayınız!
En Çok Aranan Kelimeler
ArkaplanEğriGrafikselresimlemedekoratifsanatDesensatırKusursuz.süsyinelemürekkepögeleryaratıcıDuvar KağıdıTekstilgeometrikYazdırkumaşDalgacıkÇizgilerSiyah ve beyazsoyut sanatsimple. op artBenzer İçerikler


Özel Boyut
(7952 x 5304, jpg)
Geniş Lisanslama
(7952 x 5304, jpg)
Eser Sahibi:
Tarih:
Warning: substr_count(): Empty substring in /home/lisansio/public_html/wp-content/themes/telifport_v3/inc-frontend/modal-urun-bilgileri.php on line 288